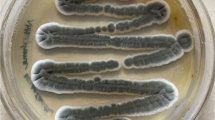

Abstract
Gibberellins represent an important group of potent phytohormones, growth-promoting, closely related diterpenoid acids biologically derived from tetracyclic diterpenoid hydrocarbon. Among these, gibberellic acid (GA3) has received the greatest attention. GA3 is a highly valued plant growth regulator which has various applications in agriculture. It is extensively used for beneficial effects including stem elongation, elimination of dormancy, sex expression, seed germination, flowering, and fruit senescence. Along with plants, many microbes are also producing GA3 as their secondary metabolite, and among these, fungi are reported to produce a higher amount of GA3. Fermentation technology based on submerged fermentation and solid-state fermentation for the production of GA3 has been used with its merits and demerits using Fusarium moniliforme fungus in the industry. Several mathematical models and optimization tools were also designed for enhancing the fermentative yield by researchers. The detailed analysis is essential to understand all the fermentation aspects, various unit parameters, process operation approaches, reduction in cost, and assessment of the possible uses of these models in the production of GA3 for higher yield. Recently, exclusive research is executed to lower down the production cost of GA3 approaching various strategies.
Similar content being viewed by others
Explore related subjects
Discover the latest articles, news and stories from top researchers in related subjects.Avoid common mistakes on your manuscript.
Introduction
The importance of the agricultural sector to the national economy conveys the search for alternatives to increase the production of food and raw materials. Plant hormones are then perceived as an important input to increase the technical and economic efficiency of agricultural production systems. Plant hormones play a vital role during the various stages of growth and development. In that, gibberellic acid has worldwide consideration due to its valuable applicability in the agricultural and brewing industry. Now, the bulk production of this natural plant hormone is fulfilled by the fermentation technology using Fusarium moniliforme. This fungus was earlier known as Gibberella fujikuroi [1]. Various stages of upstream and downstream processes are required parameters to understand GA3 production specifically when fungal cells are used. Strain selection, strain improvement, inoculum development, ensuring the viability of economic raw materials for the production, extraction methods, and GA3 recovery from the fermentation medium are the major concerns effective to GA3 fermentation.
Chemistry of GA3
GA3 is the part of gibberellin group. Gibberellin refers to a large group of diterpenoid carboxylic acids which are categorized based on their structure (Fig. 1). They contain four isoprene units in their basic structure and are classified into two groups: C20 and C19. All the gibberellins have either 19 or 20 carbon structures containing the ent- gibberelllane skeleton [2]. Subscribed numbers GAn are used to characterize gibberellins traditionally, where "n" commonly indicates the sequence of the discovery [3]. For example, GA3 or gibberellin A3 is termed for gibberellic acid.
GA3 is the most prevalent gibberellin, isolated from Fusarium fujikuroi and the first had been structurally described. It is characterized chemically as tetracyclic dihydroxy-γ-lactone acid, containing a double bond at C1–C2, γ-lactone ring at C-10, and a hydroxyl group in C-13 [4]. Early chemical characterization of the saturated γ-lactone ring was done by infrared spectra having a band near 1780 cm−1; the presence of two ethylenic bonds was detected by Cross [5] using microhydrogenation. The ultraviolet spectrum of pure gibberellic acid showed only end absorption and ruled out the presence of a conjugated system [6]. The physicochemical properties are mentioned in Table 1.
GA3 is one of the slightest steady compounds among all GAs, including its aqueous solutions [8]. It cannot be decomposed in dry conditions but rapidly decomposed in hot conditions and aqueous solutions. At 20 °C, the aqueous solution of GA3 has a half-life near to 14 days [9]. The stability can be related to a C1–C2 double bond in chemical structure and that is making the molecule more bioactive according to Albermann et al. [10].
GA3 decomposition products can be distinguished when various physical factors such as temperature, pH of the solution, and the time of reaction are applied to the GA3 solution. Due to that changes in the structure of the GA3, its effectiveness on a plant may be changed [11]. A detailed study of GA3 reactions and derivatives was published by Cross [5] and Hanson [12].
Biosynthetic Pathway of GA3
The descriptive literature on GA3 biosynthesis and regulation was deliberated by MacMillan [13], Salazar-Cerezo et al. [14], Kawaide [15], Hedden and Sponsel [16], and Rademacher [17] in plant, fungi, and bacteria. A brief note on GA3 biosynthetic pathway in fungi is included here in Fig. 2. The general pathway was defined in the 1960s and early 1970s, where GA3 was considered the end product of gibberellin biosynthesis found in F. moniliforme. It was determined by feeding 14C-labelled acetate and mevalonate to mutant strains in which specific steps of the pathway were blocked [18].
Biosynthetic pathway of GA3 in F. moniliforme [9]
The genes responsible for GA3 formation in the fungi are systematized in clusters, which are found on chromosome 4 in Fusarium fujikoroi, where they are organized in a cluster of 7 genes [14]. Another fungus, Sphaceloma manihoticola showed similarities with F. fujikoroi except for two genes [19].
GA3 is formed as a diterpene via the isoprenoid biosynthetic pathway. It is initiated with mevalonic acid, which is converted to geranylgeranyl pyrophosphate (GGPP) in the cytosol [17] via isopentenyl, dimethylallyl, geranyl, and farnesyl pyrophosphates in fungi [20].
GGPP is then converted to ent-kaurene, which is the first intermediate in GA3 biosynthesis. The formation of ent- kaurene significantly increases the specificity. Copalylpyrophosphate is worked as an intermediate in this reaction, and the two steps are catalysed by ent-kaurene synthetase [17]. Synthesis of ent-Kaurene is a pathway branch that perpetrates the cell to the production of either GA or alternative products. This ent-kaurene is oxidized into ent-7a-hydroxykaurenoic acid via stepwise oxidation [18].
By contracting the B ring and further oxidizing at C-6, the compound converted later into GA12-aldehyde. GA12 aldehyde is converted into GA14 in which first 3β- hydroxylation forms GA14 aldehyde and then oxidation at C-7 to form GA14. This GA14 is converted into GA4 subsequently by 20-oxidation and the formation of a lactone ring [1]. F. moniliforme 's main product of gibberellin biosynthesis is GA3, which is formed after the GA4 via GA7 by 1,2-dehydrogenation (GA4→GA7) and 13-hydroxylation (GA7→GA3) [21].
Production of GA3
GA3 is naturally produced by plants and microorganisms, more specifically by fungi and bacteria. The plant contains just a few micrograms of gibberellins per kilogram of fresh weight in vegetative parts of plants [8]. Among them, the amount of GA3 extracted from the plant tissue was relatively low and the extraction technique was time-consuming. As a result, it is no longer commercially viable for gaining GA3.
However, only a few researchers attended the procedure for the chemical method of GA3 synthesis. Corey et al. [22] utilized 2-allyloxyanisole as the starting point for a retrogressive synthesis, whereas Hook et al. [23] attempted a complete synthesis of GA3 using the hydrofluorene route. Apparently, Nagaoka et al. [24] described a highly stereo-controlled route for the total synthesis of ( ±)—gibberellic acid. These synthesis procedures require the use of costly chemicals and many stages. As a result, the chemical synthesis of GA3 is no longer employed.
Microbial fermentation is extensively utilized for the manufacturing of GA3 at the industrial level. The commercial production of GA3 at a laboratory scale was initiated by ICI in 1954. Earlier liquid surface fermentation (LSF) was the prime technique for production but it was incapable in terms of advantages and now, many industries are producing GA3 by SSF and SmF [8]. However, Oliveira [25] explored the semi-solid-state fermentation mode for GA3 production using citric acid pulp.
Strain Selection
Originally from the culture filtrate of Gibberella fujikuroi, the first time gibberellins were isolated. Besides Gibberella fujikuroi, other fungi were also reported to produce GA3, but mostly in lesser quantities [21] and not beneficial at commercially viable levels [26]. Borrow et al. [27] tested 21 strains isolated from several host plants for their capacity to synthesize GA3. Another researcher, Sanchez-Marroquin [28] worked on Fusarium spp. and tested 43 strains for GA3 production in which F. moniliforme was able to produce a greater yield of GA3. Therefore, Fusarium spp. is the preferable choice for GA3 research. The isolation method and the presence of Fusarium spp. were documented by Leslie and Summerell [29]. Choi et al. [30]; Bhalla et al. [31], and Ahmad et al. [32] mentioned the isolation procedure and screening of GA3-producing fungi.
After Gibberella fujikuroi and Sphaceloma manihoticola, Nurospora crassa is the third fungus shown to produce GA3. It is worth noting that GA3 is primarily found in the mycelia of Neurospora crassa, whereas Gibberella fujikuroi and Sphaceloma manihoticola secrete GA3 into the medium [33].
Strain Improvement
Natural isolates have low production capacity as compared to optimized and developed strains. Hence, strain improvement is required for higher production as well as for its stability. Strain development has been accomplished by natural recombination, mutagenesis, and genetic engineering [34]. Mutagenesis is a common approach where mutagenic agents are used including X-rays, UV, gamma radiation, and chemical mutagens for strain improvement. Sleem [1] studied the effect of different doses of 60Co gamma radiation on fungus growth and the production of GA3. Lale [9] applied UV radiation, ethyl methyl sulphonate (EMS) treatment, and a combination of UV + EMS treatment for mutagenesis intended for the enhancement of GA3 production.
Recombination of DNA such as protoplast fusion was approached by Lale [9]. The researcher used yeast cell Trichosporon cutaneum (NCIM 3352) and a mutant strain of F. fujikuroi for recombination. Combined fusant Mut32 tested for the higher production of GA3. Genetic engineering approach for GA3 using CRISPR/Cas-9 based on genome editing in F. fujikuroi was developed by Shi et al. [35]. In that altering metabolic pathway, such as the elimination of ppt1 gene, P-450-3 gene affected the other GAs metabolites and induced their production. But it was not suitable for GA3 [36,37,38]
Inoculum Preparation
Inoculation of vegetative cultures and subsequent inoculum development are the essential steps in the production of secondary metabolites. The quality and quantity of inoculum have a significant impact on GA3 production. The conditions in which hyphae fragmented as the vegetative inoculum when it aged and autolysis began in the production medium are not suitable for production [21].
Inoculum for large-scale fermentation is prepared progressively in several submerged culture stages until enough mycelium volume is available. The first fungal culture was streaked onto potato dextrose agar (PDA) Petri plates and incubated for 7 to 10 days at 28 °C. Then 12 mm diameter of agar having mycelium was placed in 250 mL Erlenmeyer flasks with a 100 mL fermentation medium [39].
An aqueous suspension of spore inoculum was prepared from 7- to 10-day-old PDA slant culture in which an adequate amount of distilled water [40] or Tween 80 water [41] was added into the slants. Then the spores were scraped and collected into a sterile flask. By this, conidia and mycelium fragments combine to form the suspension. From this, 1 × 106 spores/ mL were inoculated into Czapek–Dox (CD) broth for the inoculum preparation. Later on, they were added to the fermentation medium [42]. The schematic diagram of the fermentation process for GA3 is mentioned in Fig. 3 [34].
Production Modes
At the initial level, liquid surface fermentation (LSF-fermentation in static condition with liquid medium) mode was used but the current scenario of GA3 production is based on solid-state fermentation (SSF) and submerged fermentation (SmF) modes. Therefore, the study of SSF and SmF for GA3 fermentation is discussed here. Other modes of fermentation were reviewed by Kumar and Lonsane [8]; Oliveira [25]; Camara et al. [4].
Submerged Fermentation (SmF)
SmF is the production mode in which microorganism grows in a liquid medium that has been optimized with the necessary nutrients, physical, and chemical parameters for better production of desired metabolites. The production of a metabolite is correlated to the growth pattern of microbes. This requires carefully growing the selected microorganisms in a closed reactor for industrial production or in a flask that enabled laboratory scale production containing the fermentation medium. The medium used in the SmF process is naturally free-flowing. This differentiates it from the SSF technique, whereas the use of a medium in greater depth extricates it from the liquid surface fermentation (LSF) process. The use of a medium in deep layers in the SmF process provides many advantages, including operational convenience, economy, reduced space requirements, improved accuracy in inoculation and growth pattern, enhanced contamination control, and efficient control of parameters [8]. Nutritional parameters, carbon and nitrogen (C:N) ratio, the optimized volume of inoculum, and controlled physical parameters like temperature, pH, dissolved oxygen, etc., affect in greater extent to the SmF technique for GA3 production. Several researchers had denoted the SmF data for better GA3 production mentioned in Table 2.
The Physiology of GA3 formation
GA3 as a secondary metabolite was confirmed by the lower production before nitrogen exhaustion in nitrogen-limited media, bulk production after nitrogen exhaustion, and termination of the production after the glucose exhaustion in glucose-limited media. The growth phases of G. fujikuroi related to the GA3 were studied by Borrow et al. [27]. These phases were also reviewed by Kumar and Lonsane [8] and Machedo and Soccol [43].
When the spores were inoculated as an inoculum directly in the medium, the first phase—the lag phase could be observed for up to 90 h [27]. When the nitrogen-limited medium is utilized, the lag phase is untraceable as the strain needs little or no adaptation if the added inoculum is mycelium cells. But the phase is noticeable when more than 30% glucose is consumed from the carbohydrate-rich or ammonium acetate medium [8]. The second phase is a balanced phase in which growth comes to be exponential initially and later on becomes linear. The uptake of nutrients like glucose, nitrogen, and other salts is near to constant per unit increase in biomass weight then cells undergo the deceleration stage due to oxygen restriction. The production of GA3 is not initiated in this phase [43]. The following stage is the transition phase in that, the mycelium composition differs from the balanced phase due to the phosphate and magnesium limited medium. The next is the storage phase in which increases in dry weight. In this phase, the carbon source mainly glucose presented in excess whereas the nitrogen source is exhausted. The accumulation of carbohydrates, lipids, and polyols can be noticed. The GA3 production is initiated in this phase and continued in the presence of available glucose [8]. Later on in the maintenance phase, dry weight remained constant, and the uptake of only glucose for GA3 production. If glucose is exhausted, still synthesis of GA3 is operated from the reserved fat. Finally, the nutrient is depleted and the mycelial cells break apart increasingly as compared to the maintenance phase. This phase is called the terminal phase [21].
Immobilization Technique
In the immobilization technique, the microbial cells or enzymes are fixed in a spatial range by using physical or chemical ways. Microbial cell immobilization can be classified as entrapment, adsorption, or encapsulation within natural or synthetic polymers [44]. Immobilized mycelia or pellets have numerous advantages, including contamination-free products and easy reaction stoppage by removing fungal cells. Immobilized growing cells have been shown to provide benefits such as improved stability and faster removal of end products from fermentation vessels. Cell adhesion is preferable to encapsulation and entrapment because it requires a simple preparation method. This can be useful for the preservation of the cell's viability and activity. The main disadvantages of these techniques are cell release due to weak binding to carriers and high production costs [1].
According to Lu et al. [45], GA3 production by immobilized G. fujikuroi on polymeric fibrous carriers was maintained at a constant value of about 210 mg L−1 over 84 days in flask cultures during 12 consecutive batch fermentation cycles. Escamilla et al. [46] optimized the pH, C:N ratio, rice flour concentration, and temperature in a batch fluidized bioreactor for GA3 production using immobilized G.fujikuroi in Ca-polygalacturonate. The obtained product concentration was three times higher than those reported earlier for either suspended or solid culture. Kim et al. [47] investigated the performance of immobilized G. fujikuroi for GA3 production on celite beads and concluded that the repeated incubations of immobilized fungal cells increased cell concentrations and volumetric productivity. The maximum volumetric productivity obtained in the immobilized cell culture was three times that of the suspended cell culture.
Solid-State Fermentation (SSF)
In the absence of free water, solid-state fermentation is described as fermentation that unfolds over a non-soluble material and serves as both physical support and needed nutrients. The SSF method entails growing moulds on a moist solid substrate in a suitable fermenter/flask under optimal growth conditions to get the maximum potential yields. Growth in flasks was allowed in laboratory scale fermentations. Kumar and Lonsane [8] enlisted the advantages of the SSF technique over SmF which are relevant for GA3 fermentation by SSF.
Table 3 summarizes the various studies on the production of GA3 by SSF mode. The data incorporate a variety of substrates such as wheat bran, coffee husk, maize cob particles, cassava flour, and many more [8, 54,55,56,57]. Incubation times and temperatures vary across the data. However, the temperature range was 28–30 °C except for Paecilomyces sp. ZB which was 37 °C [59].
Factors Affecting the Production of GA3
Regardless of the fermentation method used, the chemical and physical conditions are critical for the development of fungi and the production of their metabolites [4]. Secondary metabolite synthesis is primarily determined after the maximum biomass formation. As a result, the medium component selection is based on both growth and product formation. A fast enrichment of GA3 at high concentrations is a criterion for medium composition and other ingredients.
Carbon and nitrogen sources are the most important nutrients influencing GA3 production. Glucose and sucrose have frequently been used as carbon sources. However, if the initial amount of glucose was greater than 30%, the specific growth rate and rate of production were reduced. Feed processes were implemented in response to the inhibitory effect of high glucose levels on productivity. Glucose was added at regular intervals during the production phase, and the concentration was kept below 4%. Another way to avoid the inhibitory effect of glucose is to use carbohydrate polymers such as starch and plant meals that contain a mix of quickly and slowly metabolized carbon sources [21]. Carbon sources for GA3 production are typically glucose and sucrose. Other carbon sources such as mannitol, maltose, starch, and glycerol have also been described as GA3 production medium [8, 43, 55].
The presence of nitrogen in the medium is critical for GA3 production. However, GA3 synthesis does not begin until the nitrogen is depleted from the medium [27]. Organic sources such as corn steep liquor, plant oil, and inorganic salts such as ammonium sulphate, ammonium chloride, and ammonium tartrate are used as nitrogen sources [4].
The C:N ratio is another useful factor that managed to improve GA3 yield. Agro-industrial residues have been extensively reported as carbon or nitrogen sources for GA3 production using various fermentation systems. This practice is undoubtedly useful also reducing the environmental impact and allowing for a possible cost reduction in obtaining the final product. [20, 60]
Temperature, pH, agitation, aeration, water activity, and humidity are physical parameters that affect GA3 production [49]. Depending on the strain, the ideal temperature ranges from 25 to 32 °C. The commonly used pH range of 3.5–5.8 is appropriate for GA3 synthesis [59]. The biosynthesis of GAs needs a series of oxidative processes; hence, aeration is absolutely required. As a result, the fungus's requirement for oxygen might increase as mycelium grows. Agitation should allow for efficient homogenization and mass transfer of oxygen inside the flask or fermenter [19, 43].
The production of many metabolites requires the addition of salts and trace elements along with carbon and nitrogen sources including magnesium, potassium, phosphate, and sulphate. Despite this, the impact of trace elements on the microbial synthesis of GA3 is still poorly understood [60]. The need for trace elements was frequently satisfied by contaminants in commercial media [8, 21, 27]. The range of magnesium and potassium was up to 2 g/L and 7 g/L, respectively, whereas the rest of the trace elements like salts of iron, zinc, and copper were added with less than 0.1 g/L concentration in the media [45, 48, 53, 60].
Optimization Tools
Optimization is an experimental design in which the production of any metabolite is enhanced at the end. Before any optimization, the screening of effective parameters that affect production must be checked. In that, a fungal strain or the factors that affect the growth can be improved and finalized for optimization. Various statistical tools are useful for this purpose. Here, a number of runs are considered as a number of flasks having all the factors/variables in a particular unit/level prescribed by the optimization tool.
Optimization of GA3 fermentation has been reported by many researchers. Ben-Rhouma et al. [61] showed the complied optimization tools for GA3 production for Fusarium oxysporum in SSF. They initiated the screening for additional nutrients by a Plackett–Burman design having 13 variables- inoculum size, NH4NO3, urea, fish meal, NaNO3, molasses, date waste, sucrose, barley bran, wheat straw, sesame bark, wheat bran, and (NH4)2SO4- with 2 levels. After finding the most affecting factors, Taguchi L25 (orthogonal array) methodology with six factors with 3 levels was used for understanding the relationship between the factors of a medium component. In that sesame bark, wheat straw, NaNO3, date waste, urea, and (NH4)2SO4 with 3 levels were performed having 25 runs. The result was an increased 7.14 g/kg GA3 as compared with initial production 2.72 g/kg. After obtaining the significant factors, Box-Behnken Design (BBD) Response Surface Methodology (RSM) was executed to find optimum conditions for the highest GA3 fermentation with a quadratic model having date waste, NaNO3, urea, (NH4)2SO4, and as factors. After optimization, the final production of GA3 was achieved 8.16 g/kg.
BBD-RSM was also implemented by Isa and Mat Don [62] with incubation time, inoculum sizes, and precursor concentration (olive oil) as independent variables selected with 3 levels having a total of 17 runs in SSF. Optimized condition after experiment was concluded as -incubation time 7 days, inoculum size 21% (v/w), and 2% (v/w) olive oil concentration. After fermentation, GA3 concentration reached 31.95 mg/kg substrate which increased by 16.7% as compared with initial unoptimized media.
Orthogonal experimental design L9 (34) reported by Escamilla et al. [46] using G. fujikuroi. In that temperature, pH, C:N (glucose:NH4Cl), and rice flour concentration were taken as factors with 3 levels in the fluidized bioreactor having 9 runs total in SmF. Immobilized medium beads were added for fermentation. In the end, the final 3.9 g/L GA3 production was achieved which was 3 times higher than the initial 1.1 g/L production.
Rodrigues et al. [57] adopted a simplex lattice design with six factors in the form of six agro-industrial residues using 5 fungal strains. The substrates utilized for GA3 SSF were citric pulp, soy husk, cassava bagasse, soy bran, sugarcane bagasse, and coffee husk. Among these, the citric pulp (CP) resulted in the highest production of GA3 5.9 g /kg of dry CP in SSF after the optimization.
Mathematical models were also exploitable as an optimization tool. With limited assumption, GA3 production correlated to a specific growth rate of organism was characterized by Monod type relationship and that was developed based on batch kinetics in SmF [48]. Another model was moulded by Gohlwar et al. [63] using milk permeate as a medium for GA3 production in SmF. In this model, the dependence of GA3 production with various fermentation parameters was analysed by a non-linear multiple regression model.
Downstream Processes
Downstream processes (DSP) comprise the post-fermentation processes. It is operated when the fermentation system contains a higher quantity of desired metabolites. These processes aim to recover the product with its original potentiality from the system. DSP can be divided into a series of distinct unit processes linked together to accomplish the product purification [34].
Various factors are affecting these recovery and purification steps including morphology of the organism, by-product present in the medium, and mode of production. The cost of DSP is higher in SmF as compared to SSF and SSSF media [4].
Primary Recovery
The physical and chemical properties of the product, as well as its concentration and location, are apparently key factors as they determine the initial separation steps and the overall purification strategy. In some cases, pre-treatment is required to avoid inactivation or degradation of the product. Because of handling, spillage, and other related factors, some quantity of product loss is inherent in all of this downstream processing [8].
The first step in GA3 recovery begins with filtration and centrifugation for the removal of larger particles from the medium and separation of mycelia or pellets from the culture filtrate [54]. In general, SSF and SmF show similarities in the recovery process after obtaining the filtrate that contains fermented GA3. In SSF, the supernatant is acquired by adding various solvents to the medium and then stirring under optimal conditions to achieve uniformity then followed by centrifugation and filtration processes, whereas in SmF, the fraction of fermented medium in the form of a sample can be collected then filtration and centrifugation are performed. The supernatant is used for GA3 extraction. Another technique such as supercritical fluid extraction or multiple countercurrent leaching could be used for the extraction [4].
Several data were collected in SSF for the primary extraction, which includes the addition of various solvents as well as their mixing durations, and centrifugation rates related to the solid media and subsequently fermentation completion.
Solid cultures were milled after drying for 24 h at 40 °C. The dried sample was then extracted overnight with a 100 mL mixture of ethanol and water (1:1, v/v) [64]. Whereas Bandelier et al. [54] stated a 10% (v/v) ethanol aqueous solution at a solid medium to solvent ratio of 1:3. At 25 °C, the solution was mixed at 100 rpm for 1 h. Phosphate buffer (pH 8.0) was added to fermented media and mixed for 1 h [57]. Distilled water [51], 70% methanol [58], and butanol [65] were also employed as mixing solvents. Further, crude samples were centrifuged at a range of 4000 to 12,000 rpm [66, 67] in SSF and SmF. After centrifugation, the liquid fraction is used for the extraction of GA3 and for the rest of the downstream processes.
When compared to many other secondary metabolites, the concentration of GA3 is low in the medium after the fermentation. As a result, recovering GA3 from fermentation broth necessitates handling a considerable volume of liquid to separate a relatively small amount of GA3.
Extraction of GA3
The cell-free extract is then subjected to adsorption, liquid–liquid extraction, or clarification steps. The most commonly used technique is repeated liquid–liquid extraction followed by a vacuum evaporator for concentration [68]. New industrially viable GA3 recovery techniques and the optimization of existing techniques are still necessary to lower downstream costs and reduce GA3 losses that typically occur [4].
Adsorption
Metabolites can be purified and separated through adsorption. To separate the desired metabolite, an adsorbent column packed with a solid resin with an affinity to the solute is used. Metabolite is then recovered from the loaded resin while the other components of the solution flow through the system. This resin can be reused for subsequent cycles [69].
The polarity of GA3 is lower; hence, resin with moderate polarity showed a higher adsorption effect [4]. Tang et al. [70] investigated the adsorption efficiency. The medium and weak polarity resins (X-5, S-8, and AB-5) in comparison with nonpolar (D3520, D4006, and D4020) and polar (NKA-9) resins were used by the researcher. Using S-8 resin, GA3 recovery reached 90%, and the concentration was higher compared to those extractions of GA3 without resin. XAD-16, C18, and activated charcoal were also utilized to remove impurities whereas activated charcoal has proven efficient material for adsorption [71].
Liquid–Liquid Extraction
It consists transfer of the GA3 from one solvent to another solvent that has more affinity. Ethyl acetate is used commonly for liquid–liquid extraction that solubilizes GA3 from the aqueous phase [72]. Instead of ethyl acetate, Uslu et al. [73] illustrated tridodecylamine as an extractant dissolved in three solvents (Isoamyl alcohol, octane-1-ol, and decane-1-ol) for liquid–liquid extraction. In that isoamyl alcohol displayed 96.37% extraction efficiency as compared to others. However, liquid–liquid extraction necessitates a large volume of solvents, and their recovery amount is comparatively reduced from the original volume which results in a significant solvent loss.
An aqueous two phase system (ATPS) is advantageous for extraction of GA3 in which mutual incompatibility of two polymers or a polymer and a salt in aqueous solution formed this ATPS. Polyethylenimine (PEI) / Hydroxyethylcellulose (HEC)-based ATPS for extraction was explored by Shukla et al. [68]. In a cell-free stream, by properly designed ATPS is quite useful to overcome the problem of low product extraction.
Emulsified Liquid Membrane
Using emulsion liquid membrane (ELM) technology, Berrios et al. [74] investigated the extraction of GA3. The system used in this study was water in oil emulsion consisting of KCl aqueous solution and n-heptane stabilized by the surfactant SPAN 80. Aliquat 336, a common carrier, was added to the organic phase to improve mass transfer and selectivity. The extraction yield was 68% with a 2.2-fold increase in concentration. These findings imply that GA3 extraction using ELM is entirely feasible.
Purification of GA3
Specific details about the purification steps are usually not published but kept by every manufacturing company as confidential business information. Researchers follow repeatedly liquid–liquid extraction and then the organic phase was subjected to treatment with Na2SO4 for removal of water. A repeated procedure of extraction can be performed for the elimination of impurities. At last, this solvent is followed by vacuum evaporation and drying for the crystallization of GA3 [75].
GA3 Analysis and Estimation
GA3 analytical procedures are classified into two types generally as biological assays and physicochemical methods. Bioassays are used when a high level of specificity and sensitivity is mandatory but they are not appropriate when fermentation is operated and analysis of GA3 is constantly monitored. Physicochemical instrumentation methods such as colorimetric, spectrophotometric, and fluorometric methods are relatively simple and can be completed within a short period hence commonly preferred in fermentation industries. However, these methods have the disadvantage of requiring pre-treatment of the sample to remove interfering substances present in the fermentation broth [8, 76].
Spectrophotometric Method
Holbrook et al. [77] described GA3 spectrophotometric quantification at 254 nm. In brief, this method involves adding HCl to the sample and measuring the absorbance at 254 nm after 75 min. During this time, the absorbance reaches a maximum and then gradually decreases. This method is simple and quick, making it ideal for measuring higher concentrations and a larger number of samples, but it is not specific to GA3. Through broth acidification with HCl, GA3 is converted into gibberellenic acid [76]. However, high purity of broth samples is required for this method to avoid interruptions during estimation, particularly when the fermentation media are not defined.
Berríos et al. [76] modified the above estimation method. The author showed that the conversion of GA3 into gibberellenic acid is linear and this linearity can be seen within 2 min after the addition of HCl. Therefore, the incubation period is reduced from 75 min, and recording the absorbance at 254 nm with each 20 s intervals up to 2 min after adding 3.75 M HCl immediately. This method has a sensitivity threshold of 0.1 g and accuracy is greater than 97% for GA3 concentrations ranging from 0.1 to 1 g L −1.
Graham and Henderson [78] mentioned a producible and quantitative method for GA3, ranging the concentration from 5 to 50 μg/mL. Folin—Wu phosphomolybdic acid reagent was mixed with purified broth and incubated at 100 °C for 1 h. After incubation, the absorbance was calculated at 780 nm. If sodium tungstate was removed from the reagent, then absorbance should be measured at 660 nm. Another colorimetric estimation was illustrated in which the absorbance was taken at 730 nm when GA3 reacted with the Folin-Ciocalteu reagent [79].
The alkaline 2,4-dinitrophenylhydrazine (DNPH) method for estimating GA3 was successfully adapted by Graham and Thomas [80]. GA3 reacts with acidic 2,4—dinitrophenylhydrazine. The resulting product possibly the 2,4—dinitrophenylhydrazone of gibberic acid, treated with alcoholic potassium hydroxide at 100 °C for 5 min, produces a stable wine-red colour. The intensity of the colour is proportional to the amount of GA3 present when it is measured at 430 or 540 nm. A similar estimation procedure was stated by Desai [81].
Chromatographic Method
As compared to the spectrophotometric methods, chromatographic methods are more reliable, sensitive, and accurate for the analysis of GA3. These methods enable the qualitative as well as quantitative determination of GA3 after the purification steps.
High-Performance Liquid Chromatography (HPLC)
HPLC is the appropriate technique for biomolecule analysis. In HPLC, the mobile phase is a liquid carrier stream that transports the injected sample through the separation column and to the detector. Individual components are separated in the separation column based on physicochemical interactions, and the elution order is determined by such interactions. The separated components are detected by the detector based on the absorption of light or changes in refractive index, electrochemical/conductivity changes, or simply the size distribution of eluting molecules.
The UV detector is commonly used in HPLC for the assay of GA3 from the fermented broth. Several published data for GA3 analysis by HPLC are mentioned in the following Table 4.
Thin-Layer Chromatography (TLC)
Thin-layer chromatography is a method for identifying primarily GA3 after purification steps. It can be used for quantification based on colour intensity but is not reliable. However, it is a cheaper method for the detection of GA3 as compared to HPLC. Following the completion of the chromatographic separation on silica paper, colour development solvents are sprayed and visualized under ultraviolet light. The retention factor and colour specification of standard GA3 are considered when extracted GA3 sample is testified by TLC. Few data on TLC for GA 3 are listed in Table 5.
Fourier Transform Infrared Spectrometer (FT-IR)
FT-IR is used to assess the purity as well as the functional group of the compound. Qualitative analysis of plant hormones such as GA3 can be analysed through FT-IR as the method. It can be done for the purified GA3 obtained from the fermentation by comparing it with the standard solution or powder of GA3 using the method described by evaluating both spectra results that indicate the qualitative analysis of GA3. The transmittance was carried out in the form of potassium bromate (KBr) pellets in the range of 400—4,000 cm−1 and the chromatograph of GA3 was mentioned by Omojasola and Adejoro [40].
Gas Chromatography-Mass Spectrometry (GC–MS)
A heated injector is used to introduce samples into the GC capillary column to act as a stationary phase. Inert gases like helium or nitrogen are used as carrier gas/ mobile phase. Components are separated into a column based on a combination of molecular mass and polarity. Then, it enters in the MS source sequentially via a heated transfer region. The MS is an analytical instrument that generates a beam of gas ions from samples and sorts the resulting mixture of ions using electrical or magnetic fields. It provides a digital output signal (peaks) from which the mass-to-charge ratio and intensity of each detected ionic species can be determined.
Method parameters for GA3 analysis by GC–MS were cited by Suwannasom et al. [88]. In that, the capillary GC column used was a ZB-5 (30 m × 0.25 mm i.d., Zebron). The following conditions were used: the column temperature was held at 150 °C for 2 min then increased at 20 °C /min to 280 °C and maintained for 2 min; helium was used as the carrier gas at a linear flow rate of 1 ml/min. The injection and interface temperatures were 250 °C and 280 °C, respectively. Electron energy was 70 eV. Extracted GA3 was identified by comparing their mass spectra to authentic GA3 spectra.
Another GC–MS programming parameter was mentioned by Choi et al. [30]. The authors have described conditions as follows: sample volume was 1 μL; Helium as carrier gas; column temperature program – 1 min hold at 60 °C, then to rise at 15 °C min−1 to 200 °C followed by 5 °C min−1 to 285 °C. The GC was connected directly to a MS Detector, which had an interface and source temperature of 280 °C, an ionizing voltage of 70 eV, and a dwell time of 100 min.
Other Methods
A lower amount near 4.97 nmolL−1 of GA3 can be quantified by a modified graphite pencil electrode [89]. An electrochemical sensor based on 5-ethyl 5-phenyl barbituric acid (EPBA) / Polyvinylpyrrolidone (PVP) with modified pencil graphite (PG) electrode was constructed in this method for quantification of GA3.
Apart from this method, fluorometric and spectrofluorodensitometric methods for the estimation of GA3 were also notably used [4, 8, 22]. With the help of the radioimmunoassay technique, femtomolar quantities of GA3 were determined by Weiler and Wieczorek [90].
A nuclear magnetic resonance (NMR) spectrometer was used to confirm the structure of purified GA3. A Brucker AV 500 MHz NMR spectrometer was used to record 1H NMR spectra of GA3 in deutero-chloroform [10].
Applications
GA3 is available in a variety of forms including soluble powder, liquid, tablet, water-dispersible granular, and wet powder. The shelf life as well as the stability reduced when the liquid formulation of GA3 was accomplished in water. As a result, GA3 is frequently dissolved in alcohol. GA3 in solid and liquid forms has some disadvantages in terms of transportation, storage, and use [4]. Formulation types and examples of commercial products of GA3 were reported by Camara et al. [4] in their review article. The cost of GA3 in the market is varying based on the type of formulation, purity, and concentration of GA3 in a particular product.
GA3 is one of the most commercial and physiologically effective gibberellins for industrial and agricultural applications so far [22]. GA3 is significantly used as a plant growth regulator and the benefits include increased crop production and quality.
As malted barley is the primary raw material used in beer production, malt quality is crucial to the end product's quality. The development of the malting process in the brewing industry is expensive and time-consuming. Hence, GA3 is widely used for the malting process. 7–10 days is the normal steeping and germination time, whereas the addition of GA3 can cut the time down to 1–3 days [21].
GA3 is applied to the crop exogenously by various methods like foliar spraying, seed priming, and plunging. The application range of GA3 is 100–150 ppm, 10–6 M [91, 92]. Some of the effects on plants by GA3 are mentioned in the following Table 6.
Future Prospects
GA3 is a member of the gibberellin family of plant growth regulators. Commercial production of GA3 using high-yielding strains is used in agricultural farms for rapid crop production and flowering that comprise green revolution to meet global food requirements. For that, the essential subjects connected to GA3 fermentation, analysis methods for GA3, and application were discussed in this paper. Solvent extraction, adsorption, and concentration with higher purification procedures are commonly used in downstream processes of GA3. Nowadays, much more attention is needed for the large-scale production of GA3 with low-cost downstream processes, effective strain improvement, and alternative strategies of production mode. Resultantly, various production techniques are constantly being tested, yielding new perspectives for GA3 production. The hunt for novel and cost-effective GA3 manufacturing techniques would definitely expand its applicability, benefiting the productivity and quality of various cultivars all over the world.
Data Availability
Data sharing not applicable to this article as no datasets were generated or analysed during the current study.
References
Sleem DAE (2013). Studies on the bio production of gibberellic acid from fungi. Dissertation, Benha university.
Crozier A, Zaerr JB, Morris RO (1982) Reversed- and normal-phase high-performance liquid chromatography of gibberellin methoxycoumaryl esters. J Chromatogr A 238:157–166. https://doi.org/10.1016/S0021-9673(00)82722-3
Maria C, Machado M, Soccol CR (2008) Gibberellic Acid Production. In: Pandey A, Soccol CR, Larroche C (eds) Current Developments in Solid-state Fermentation. Springer, New York, NY, pp 277–301. https://doi.org/10.1007/978-0-387-75213-6_13
Camara MC, Vandenberghe LPS, Rodrigues C, De Oliveira J, Faulds C, Bertrand E, Soccol CR (2018) Current advances in gibberellic acid (GA3) production, patented technologies and potential applications. Planta 248(5):1049–1062. https://doi.org/10.1007/s00425-018-2959-x
Cross BE (1954). Gibberellic acid. Part I. J. Chem. Soc. (Resumed), 4670–4676.
Brian P, Grove JF, MacMillan J (1960). The gibberellins. In Fortschritte der Chemie organischer Naturstoffe/Progress in the Chemistry of Organic Natural Products/Progrés Dans la Chimie des Substances Organiques Naturelles (pp. 350–433). Springer.
AMS-USDA (2011) Gibberellic Acid Handling/Processing, https://www.ams.usda.gov/sites/default/files/media/Gibberellic%20Acid%202%20TR.pdf. Accessed 14 December 2011
Kumar PKR, Lonsane BK (1987) Gibberellic acid by solid state fermentation: Consistent and improved yields. Biotechnol Bioeng 30(2):267–271. https://doi.org/10.1002/bit.260300217
Lale GJ (2014). Gibberellin Production: Strain Improvement and Process Optimization in Stirred Tank Reactor. Dissertation, University of pune.(Issue August).
Albermann S, Elter T, Teubner A, Krischke W, Hirth T, Tudzynski B (2013) Characterization of novel mutants with an altered gibberellin spectrum in comparison to different wild-type strains of Fusarium fujikuroi. Appl Microbiol Biotechno 97(17):7779–7790. https://doi.org/10.1007/s00253-013-4917-7
Pérez FJ, Vecchiola A, Pinto M, Agosin E (1996) Gibberellic acid decomposition and its loss of biological activity in aqueous solutions. Phytochemistry 41(3):675–679. https://doi.org/10.1016/0031-9422(95)00689-3
Hanson JR (2018) Stereochemical aspects of some rearrangements of gibberellic acid. J Chem Res 42(6):285–290. https://doi.org/10.3184/174751918X15294211268538
MacMillan J (1997) Biosynthesis of the gibberellin plant hormones. Nat Prod Rep 14(3):221–244. https://doi.org/10.1039/np9971400221
Salazar-Cerezo S, Martínez-Montiel N, García-Sánchez J, Pérez-y-Terrón R, Martínez-Contreras RD (2018). Gibberellin biosynthesis and metabolism: A convergent route for plants, fungi and bacteria. Microbiol. Res., 208(November 2017), 85–98. doi:https://doi.org/10.1016/j.micres.2018.01.010
Kawaide H (2006) Biochemical and molecular analyses of gibberellin biosynthesis in fungi. Biosci Biotechnol Biochem 70(3):583–590. https://doi.org/10.1271/bbb.70.583
Hedden P, Sponsel V (2015) A Century of Gibberellin Research. J Plant Growth Regul 34(4):740–760. https://doi.org/10.1007/s00344-015-9546-1
Rademacher W (1994) Gibberellin formation in microorganisms. Plant Growth Regul 15(3):303–314. https://doi.org/10.1007/BF00029903
Tudzynski B, Studt L, Rojas MC (2018). Gibberellins in fungi, bacteria and lower plants: biosynthesis, function and evolution. In Annual plant reviews online (Vol. 49). doi:https://doi.org/10.1002/9781119312994.apr0534
Bömke C, Tudzynski B (2009) Diversity, regulation, and evolution of the gibberellin biosynthetic pathway in fungi compared to plants and bacteria. Phytochemistry 70(15–16):1876–1893. https://doi.org/10.1016/j.phytochem.2009.05.020
Brueckner B, Blechschmidt D, Sembdner G, Schneider G (1989). Fungal Gibberellin Production. Biotechnology of vitamins, pigments and growth factors, 383–429. doi:https://doi.org/10.1007/978-94-009-1111-6_21
Brückner B, Blechschmidt D (1991) The gibberellin fermentation. Crit Rev Biotechnol 11(2):163–192. https://doi.org/10.3109/07388559109040621
Corey EJ, Danheiser RL, Chandrasekaran S, Siret P, Keck GE, Gras, JL (1978). Stereospecific Total Synthesis of Gibberellic Acid. A Key Tricyclic Intermediate. J. Am. Chem. Soc., 100(25), 8031–8034. doi:https://doi.org/10.1021/ja00493a055
Hook JM, Mander LN, Urech R (1980) Total synthesis of gibberellic acid. The hydrofluorene route. J. Am. Chem. Soc. 102(21):6628–6629
Nagaoka H, Shimano M, Yamada Y (1989) Total synthesis of (±) gibberellic acid. Tetrahedron Lett 30(8):971–974
de Oliveira J, Rodrigues C, Vandenberghe LP, Câmara MC, Libardi N, Soccol CR (2017). Gibberellic acid production by different fermentation systems using citric pulp as substrate/support. BioMed Res Int. 2017. doi:https://doi.org/10.1155/2017/5191046
Jefferys E (1970) The gibberellin fermentation. Adv Appl Microbiol 13:283–316
Borrow A, Brian PW, Chester VE, Curtis PJ, Hemming HG, Henehan C, Jeffreys EG, Lloyd PB, Nixon IS, Norris GLF, Radley M (1955) Gibberellic acid, a metabolic product of the fungus Gibberella fujikuroi: Some observations on its production and isolation. J Sci Food Agric 6(6):340–348. https://doi.org/10.1002/jsfa.2740060609
Sanchez-Marroquin A (1963) Microbiological production of gibberellic acid in glucose media. Appl. Microbiol. 11(6):523–528. https://doi.org/10.1128/am.11.6.523-528.1963
Leslie JF, Summerell BA (2008) The Fusarium laboratory manual. John Wiley & Sons
Choi WY, Rim SO, Lee JH, Lee JM, Lee IJ, Cho KJ, Rhee IK, Kwon JB, Kim JG (2005) Isolation of gibberellins-producing fungi from the root of several Sesamum indicum plants. J Microbiol Biotechnol 15(1):22–28
Bhalla K, Singh SB, Agarwal R (2010) Quantitative determination of gibberellins by high performance liquid chromatography from various gibberellins producing Fusarium strains. Environ Monit Assess 167(1–4):515–520. https://doi.org/10.1007/s10661-009-1068-5
Ahmad N, Hamayun M, Khan SA, Khan AL, Lee IJ, Shin DH (2010) Gibberellin-producing endophytic fungi isolated from Monochoria vaginalis. J Microbiol Biotechno 20(12):1744–1749. https://doi.org/10.4014/jmb.1005.05018
Kawanabe Y, Yamane H, Murayama T, Takahashi N, Nakamura T (1983) Identification of gibberellin A3 in mycelia of Neurospora crassa. Agric Biol Chem 47(7):1693–1694
Waites MJ, Morgan NL, Rockey JS, Higton G (2009) Industrial microbiology: an introduction. John Wiley & Sons, USA
Shi TQ, Gao J, Wang WJ, Wang KF, Xu GQ, Huang H, Ji XJ (2019) CRISPR/Cas9-based genome editing in the filamentous fungus Fusarium fujikuroi and Its application in strain engineering for gibberellic acid production [Research-article]. ACS Synth Biol 8(2):445–454. https://doi.org/10.1021/acssynbio.8b00478
Wiemann P, Albermann S, Niehaus EM, Studt L, Von Bargen KW, Brock NL, Humpf HU, Dickschat JS, Tudzynski B (2012) The Sfp-type 4′-phosphopantetheinyl transferase Ppt1 of Fusarium fujikuroi controls development, secondary metabolism and pathogenicity. PLoS One. 7(5):e37519. https://doi.org/10.1371/journal.pone.0037519
Tudzynski B, Mihlan M, Rojas MC, Linnemannstöns P, Gaskin P, Hedden P (2003) Characterization of the final two genes of the gibberellin biosynthesis gene cluster of Gibberella fujikuroi: des and P450–3 encode GA4 desaturase and the 13-hydroxylase, respectively. J Biol Chem. 278(31):28635–28643. https://doi.org/10.1074/jbc.M301927200
Cen YK, Lin JG, Wang YL, Wang JY, Liu ZQ, Zheng YG (2020) The gibberellin producer Fusarium fujikuroi: Methods and technologies in the current toolkit. Front Bioeng Biotechnol. 8:232. https://doi.org/10.3389/fbioe.2020.00232
Werle LB, Abaide ER, Felin TH, Kuhn KR, Mv Tres, Zabot GL, Kuhn RC, Jahn SL, Mazutti MA (2020) Gibberellic acid production from Gibberella fujikuroi using agro-industrial residues. Biocatal. Agric. Biotechnol. 25:101608. https://doi.org/10.1016/j.bcab.2020.101608
Omojasola PF, Adejoro DO (2018) Submerged fermentation of orange albedo to produce gibberellic acid using Fusarium moniliforme and Aspergillus niger. Jordan J Biol Sci 11(2):187–194
Nwachukwu I (2017) Optimized gibberellic acid production by Fusarium oxysporum. Nigerian J Microbiol 31(1):3844–3849
Panchal RR, Desai PV (2016) Study of gibberellic acid production by solid state fermentation using Fusarium Moniliforme sheldon. Int j appl sci 4(3):402–407. https://doi.org/10.3126/ijasbt.v4i3.15588
Machedo CMM, Soccol CR (1995). Gibberellic Acid Production.
Lu J, Peng W, Lv Y, Jiang Y, Xu B, Zhang W, Zhou J, Dong W, Xin F, Jiang M (2020) Application of cell immobilization technology in microbial cocultivation systems for biochemicals production. Ind. Eng. Chem. Res. 59(39):17026–34. https://doi.org/10.1021/acs.iecr.0c01867
Lu ZX, Xie ZC, Kumakura M (1995) Production of gibberellic acid in Gibberella fujikuroi adhered onto polymeric fibrous carriers. Process Biochemistry. 30(7):661–665
Escamilla SEM, Dendooven L, Magaña IP, Parra SR, De la Torre M (2000) Optimization of gibberellic acid production by immobilized Gibberella fujikuroi mycelium in fluidized bioreactors. J Biotechnol 76(2–3):147–155. https://doi.org/10.1016/S0168-1656(99)00182-0
Kim CJ, Lee SJ, Chang YK, Chun GT, Jeong YH, Kim SB (2006) Repeated-batch culture of immobilizedGibberella fujikuroi B9 for gibberellic acid production: an optimization study. Biotechnol Bioprocess Eng 11(6):544–549. https://doi.org/10.1007/BF02932081
Shukla R, Chand S, Srivastava AK (2005) Batch kinetics and modeling of gibberellic acid production by Gibberella fujikuroi. Enzyme Microb Technol 36(4):492–497. https://doi.org/10.1016/j.enzmictec.2004.11.005
Lale G, Jogdand VV, Gadre RV (2006) Morphological mutants of Gibberella fujikuroi for enhanced production of gibberellic acid. J Appl Microbiol 100(1):65–72. https://doi.org/10.1111/j.1365-2672.2005.02754.x
Rios-Iribe EY, Flores-Cotera LB, Chávira MMG, González-Alatorre G, Escamilla-Silva EM (2011) Inductive effect produced by a mixture of carbon source in the production of gibberellic acid by Gibberella fujikuroi. World J Microbiol Biotechnol 27(6):1499–1505. https://doi.org/10.1007/s11274-010-0603-4
Rangaswamy V (2012) Improved production of gibberellic acid by Fusarium moniliforme. Microbiol Res 2(3):51–55. https://doi.org/10.5923/j.microbiology.20120203.02
Panchal RR (2016) Study of gibberellic acid production by submerged fermentation using Fusarium Moniliforme. Sheldon Int J Sci Res 5(10):113–116
Pastrana LM, Gonzalez MP, Pintado J, Murado MA (1995) Interactions affecting gibberellic acid production in solid-state culture: a factorial study. Enzyme Microb Technol 17(9):784–790. https://doi.org/10.1016/0141-0229(94)00024-L
Bandelier S, Renaud R, Durand A (1997) Production of gibberellic acid by fed-batch solid state fermentation in an asetic pilot-scale reactor. Process Biochem 32(2):141–145. https://doi.org/10.1016/S0032-9592(96)00063-5
Tomasini A, Fajardo C, Barrios-González J (1997) Gibberellic acid production using different solid-state fermentation systems. World J Microbiol Biotechnol 13(2):203–206. https://doi.org/10.1023/A:1018545932104
Machado CMM, Soccol CR, De Oliveira BH, Pandey A (2002) Gibberellic acid production by solid-state fermentation in coffee husk. Appl Biochem Biotechnol - Part A Enzyme Engineering and Biotechnology. https://doi.org/10.1385/ABAB:102-103:1-6:179
Rodrigues C, Vandenberghe LPDS, Teodoro J, Oss JF, Pandey A, Soccol CR (2009) A new alternative to produce gibberellic acid by solid state fermentation. Braz Arch Biol Technol. 52(SPL.ISS):181–188. https://doi.org/10.1590/S1516-89132009000700023
Satpute D, Sharma V, Murarkar K, Bhotmange M, Dharmadhikari D (2010) Solid-State Fermentation for production of gibberellic acid using agricultural residues. Int J Environ Pollut 43(1–3):201–213. https://doi.org/10.1504/IJEP.2010.035924
El-Sheikh MA, Rajaselvam J, Abdel-Salam EM, Vijayaraghavan P, Alatar AA, Devadhasan Biji G (2020) Paecilomyces sp ZB is a cell factory for the production of gibberellic acid using a cheap substrate in solid state fermentation. Saudi J. Biol. Sci. 27(9):2431–2438. https://doi.org/10.1016/j.sjbs.2020.06.040
Rodrigues C, Vandenberghe LPDS, De Oliveira J, Soccol CR (2012) New perspectives of gibberellic acid production: a review. Crit Rev Biotechnol 32(3):263–273. https://doi.org/10.3109/07388551.2011.615297
Ben Rhouma M, Kriaa M, Ben Nasr Y, Mellouli L, Kammoun R (2020) A New endophytic Fusarium oxysporum gibberellic acid: optimization of production using combined strategies of experimental designs and potency on tomato growth under stress condition. Int BioMed Res. https://doi.org/10.1155/2020/4587148
Isa NKM, Mat Don M (2014) Investigation of the gibberellic acid optimization with a statistical tool from Penicillium variable in batch reactor. Prep Biochem Biotechnol 44(6):572–585. https://doi.org/10.1080/10826068.2013.844707
Gohlwar CS, Sethi RP, Marwaha SS, Seghal VK, Kennedy JF (1984) Gibberellic acid biosynthesis from whey and simulation of cultural parameters. Enzyme Microb Technol 6(7):312–316. https://doi.org/10.1016/0141-0229(84)90059-0
Latus-Zietkiewicz D, Chelkowski J, Foremska E, Golinski P, Grabarkiewicz-Szczesna J, Kostecki M, Lew M, Perkowski J, Plasecki M, Wiewiorowska M, Szebiotko K (1996) Biosynthesis of gibberellic acid (GA3) and mycotoxins by F. moniliforme Sheldon and other species of Liseola section. Nat. Toxins 4(5):228–233. https://doi.org/10.1002/(SICI)(1996)4:5%3c228::AID-NT5%3e3.0.CO;2-G
Haldar B, Pal R, Sengar A, Mishra V (2017) Screening of Different Substrates for Improved Production of GA3 by Solid State Fermentation Using Fusarium moniliforme. Int j innov res sci 6(11):21535–21542. https://doi.org/10.15680/IJIRSET.2017.0611080
Darken MA, Jensen AL, Shu P (1959) Production of gibberellic acid by fermentation. J. Appl. Microbiol 7(12):301–303. https://doi.org/10.1128/aem.7.5.301-303.1959
Jaroszuk-Ściseł J, Kurek E, Trytek M (2014) Efficiency of indoleacetic acid, gibberellic acid and ethylene synthesized in vitro by Fusarium culmorum strains with different effects on cereal growth. Biologia (Poland) 69(3):281–292. https://doi.org/10.2478/s11756-013-0328-6
Shukla R, Srivastava AK, Chand S (2003) Bioprocess strategies and recovery processes in gibberellic acid fermentation. Biotechnol Bioprocess Eng 8(5):269–278
Magalhães AI, de Carvalho JC, Medina JDC, Soccol CR (2017) Downstream process development in biotechnological itaconic acid manufacturing. Appl Microbiol Biotechnol. https://doi.org/10.1007/s00253-016-7972-z
Tang Z, Zhou R, Duan Z (2000) Separation of gibberellic acid (GA3) by macroporous adsorption resins. J Chem Technol Biotechnol: Int Res Process Environ Clean Technol 75(8):695–700. https://doi.org/10.1007/s11705-008-0025-0
Rodrigues C, Vandenberghe LP, Goyzueta LD, Soccol CR (2016) Production, extraction and purification of gibberellic acid by solid state fermentation using citric pulp and soy husk. BAOJ Chemistry. 2(2):14
Rachev RCH, Pavlova-Rouseva R, Bojkova SV, Gancheva VK (1993) Isolation of gibberellic acid produced by Fusarium moniliforme. J Nat Prod 56(7):1168–1170. https://doi.org/10.1021/np50097a023
Uslu H, Datta D, Bamufleh HS (2014) Extraction equilibria of gibberellic acid by tridodecylamine dissolved in alcohols. J Chem Eng Data 59(11):3882–3887. https://doi.org/10.1021/je500773w
Berrios J, Pyle DL, Aroca G (2010) Gibberellic acid extraction from aqueous solutions and fermentation broths by using emulsion liquid membranes. J Membr Sci J 348(1–2):91–98. https://doi.org/10.1016/j.memsci.2009.10.040
Sharma S, Sharma A, Kaur M (2018) Extraction and evaluation of gibberellic acid from Pseudomonas sp.: Plant growth promoting rhizobacteria. J Pharmacogn Phytochem 7(1):2790–5
Berríos J, Illanes A, Aroca G (2004) Spectrophotometric method for determining gibberellic acid in fermentation broths. Biotech Lett 26(1):67–70. https://doi.org/10.1023/B:BILE.0000009463.98203.8b
Holbrook AA, Edge WJ, Bailey F. Spectrophotometric method for determination of gibberellic acid.
Graham HD, Henderson JHM (1961) Reaction of gibberellic acid & gibberellins with folin-wu phosphomolybdic acid reagent & its use for quantitative assay. Plant Physiol 36(4):405–408
Brückner B, Blechschmidt D, Recknagel RD (1991) Optimization of nutrient medium for biosynthesis of gibberellic acid. J Basic Microbiol 31(4):243–250. https://doi.org/10.1002/jobm.3620310402
Graham HD, Thomas LB (1961) Rapid, simple colorimetric method for the determination of micro quantities of gibberellic acid. J Pharm Sci 50(1):44–48. https://doi.org/10.1002/jps.2600500110
Desai SA (2017). Isolation and characterization of gibberellic acid (GA3) producing rhizobacteria from sugarcane roots. Bio. Disc. 8(3), 488–494. http://biosciencediscovery.com
Castillo G, Martinez S (1997) Reversed-phase c18 high-performance liquid chromatography of gibberellins GA3 and GA1. J Chromatogr A 782(1):137–139. https://doi.org/10.1016/S0021-9673(97)00427-5
Negrete-rodriguez MDLX, Chavez-parga MC, Escamilla EM (2015) Gradient reversed-phase C 18 high-performance liquid chromatography of Important Gibberellins. J Chromatogr A 22(1):500–504
Sun W, Liu C, Duan H, Niu C, Wang J, Zheng F, Li Y, Li Q (2019) Isomerization of gibberellic acid during the brewing process. J. Food Sci. 84(6):1353–1361. https://doi.org/10.1111/1750-3841.14620
Zhang B, Lei Z, Liu ZQ, Zheng YG (2020) Improvement of gibberellin production by a newly isolated Fusarium fujikuroi mutant. J Appl Microbiol 129(6):1620–1632. https://doi.org/10.1111/jam.14746
Saucedo JEN, Barbotin JN, Thomas D (1989) Continuous production of gibberellic acid in a fixed-bed reactor by immobilized mycelia of Gibberella fujikuroi in calcium alginate beads. Appl Microbiol Biotechnol 30(3):226–233. https://doi.org/10.1007/BF00256209
Puyam A, Pannu PPS, Kaur J, Sethi S (2017) Variability in production of gibberellic acid and fusaric acid by Fusarium moniliforme and their relationship. Plant Pathol J 99(1):103–108. https://doi.org/10.4454/jpp.v99i1.3811
Suwannasom P, Tansupo P, Chanthai S, Ruangviriyachai C (n.d.). Determination of Gibberellin (GA3) in Liquid biofertilizers. Gsbooks.Gs.Kku.Ac.Th. https://gsbooks.gs.kku.ac.th/51/gradresearch10/file/PMO8.pdf
Ghanbary E, Asiabani Z, Hosseini N, Kiaie SH, Kaki S, Ghasempour H, Babakhanian A (2020) The development of a new modified graphite pencil electrode for quantitative detection of Gibberellic acid (GA3) herbal hormone. Microchem. J 157:105005. https://doi.org/10.1016/j.microc.2020.105005
Weiler EW, Wieczorek U (1981). Determination of femtomo| quantities of gibberellic acid by radioimmunoassay.
Sajid M, Amin N, Ahmad H, Khan K (2016) Effect of gibberellic acid on enhancing flowering time in Chrysanthemum morifolium. Pak J Bot 48(2):477–483
Hussien Ibrahim ME, Zhu X, Zhou G, Adam Ali AY, Ibrahim Elsiddig AM, Farah GA (2019) Response of some wheat varieties to gibberellic acid under saline conditions. Agrosyst Geosci Environ 2(1):1–7. https://doi.org/10.2134/age2019.01.0003
Porat R, Feng X, Huberman M, Galili D, Goren R, Goldschmidt EE (2001) Gibberellic acid slows postharvest degreening of “Oroblanco” citrus fruits. HortScience 36(5):937–940. https://doi.org/10.21273/hortsci.36.5.937
Choi C, Wiersma PA, Toivonen P, Kappel F (2002) Fruit growth, firmness and cell wall hydrolytic enzyme activity during development of sweet cherry fruit treated with gibberellic acid (GA3). J Hortic Sci Biotechnol 77(5):615–621. https://doi.org/10.1080/14620316.2002.11511547
Koyuncu F (2005) Breaking seed dormancy in black mulberry (Morus nigra L.) by cold stratification and exogenous application of gibberellic acid. Acta Biol. Crac. Ser. Bot. 47(2):23–26
Kaya C, Tuna AL, Alves AAC (2006) Gibberellic acid improves water deficit tolerance in maize plants. Acta Physiol Plant 28(4):331–337. https://doi.org/10.1007/s11738-006-0029-7
Shah SH (2007). Effects of salt stress on mustard as affected by gibberellic acid application.
Jamil M, Rha ES (2007) Gibberellic acid (GA3) enhance seed water uptake, germination and early seedling growth in sugar beet under salt stress. Pak J Biol Sci 10(4):654–658. https://doi.org/10.3923/pjbs.2007.654.658
Cline JA, Trought M (2007) Effect of gibberellic acid on fruit cracking and quality of Bing and Sam sweet cherries. Can J Plant Sci 87(3):545–550. https://doi.org/10.4141/P06-132
Hamayun M, Khan SA, Khan AL, Shin JH, Ahmad B, Shin DH, Lee IJ (2010) Exogenous gibberellic acid reprograms soybean to higher growth and salt stress tolerance. J Agric Food Chem 58(12):7226–7232. https://doi.org/10.1021/jf101221t
Sangeetha J, Sivachandiran S (2015) Influence of Different Application Methods of Gibberellic acid (GA3) on Quality and Yield of Grapes (VitisviniferaL.). Int. J. Res. Agric. 2(6):10–14
Hassankhah A, Rahemi M, Mozafari MR, Vahdati K (2018) Flower development in walnut: altering the flowering pattern by gibberellic acid application. Notulae Botanicae Horti Agrobotanici Cluj-Napoca 46(2):700–706. https://doi.org/10.15835/nbha46211183
Miceli A, Moncada A, Sabatino L, Vetrano F (2019) Effect of gibberellic acid on growth, yield, and quality of leaf lettuce and rocket grown in a floating system. Agronomy. https://doi.org/10.3390/agronomy9070382
Pereira AdES, Oliveira HC, Fraceto LF (2019) Polymeric nanoparticles as an alternative for application of gibberellic acid in sustainable agriculture: a field study. Sci Rep 9(1):1–10. https://doi.org/10.1038/s41598-019-43494-y
Ramesh S, Sudhakar P, Elankavi S, Suseendran K, Jawahar S (2019) Effect of gibberellic acid (GA3) on growth and yield of rice (oryza sativa l.). Plant Arch 19:1369–1372
Talat H, Shafqat W, Qureshi MA (2020) Effect of gibberellic acid on fruit quality of kinnow mandarin. J Glob Innov Agric Soc Sci 8(3):59–63. https://doi.org/10.22194/jgiass/8.901
Lin SY, Agehara S (2020) Exogenous gibberellic acid advances reproductive phenology and increases early-season yield in subtropical blackberry production. Agronomy. https://doi.org/10.3390/agronomy10091317
Iftikhar A, Rizwan M, Adrees M, Ali S, ur Rehman MZ, Qayyum MF, Hussain A (2020) Effect of gibberellic acid on growth, biomass, and antioxidant defense system of wheat (Triticum aestivum L.) under cerium oxide nanoparticle stress. Environ. Sci. Pollut. Res. 27(27):33809–33820. https://doi.org/10.1007/s11356-020-09661-9
Acknowledgements
Authors are thankful to Department of Microbiology and Biotechnology, School of Sciences, Gujarat University. We acknowledge the Education Department, Government of Gujarat, India, for the providing research fellowship to J.P. and A.P. under the ScHeme Of Developing High-quality research (SHODH).
Funding
The authors declare that no funds, grants, or other support was received during the preparation of this manuscript.
Author information
Authors and Affiliations
Contributions
Jaimin B. Pandya wrote the manuscript; Aanal N. Patani prepared the figures; Vikram H. Raval and Kiransinh N. Rajput suggested the changes whereas Rakeshkumar R. Panchal corrected the manuscript.
Corresponding author
Ethics declarations
Conflict of Interests
The authors have no relevant financial or non-financial interests to disclose.
Main Conclusion
This study summarized the research on gibberellic acid (GA3) fermentation processes using fungi and recapitulated the optimization tools for higher GA3 production. Chromatographic methods such as HPLC, GC for GA3 analysis are reviewed.
Additional information
Publisher's Note
Springer Nature remains neutral with regard to jurisdictional claims in published maps and institutional affiliations.
Rights and permissions
Springer Nature or its licensor (e.g. a society or other partner) holds exclusive rights to this article under a publishing agreement with the author(s) or other rightsholder(s); author self-archiving of the accepted manuscript version of this article is solely governed by the terms of such publishing agreement and applicable law.
About this article
Cite this article
Pandya, J.B., Patani, A.N., Raval, V.H. et al. Understanding the Fermentation Potentiality For Gibberellic Acid (GA3) Production Using Fungi. Curr Microbiol 80, 385 (2023). https://doi.org/10.1007/s00284-023-03454-2
Received:
Accepted:
Published:
DOI: https://doi.org/10.1007/s00284-023-03454-2